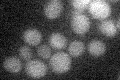
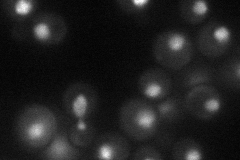
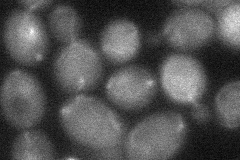
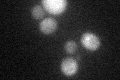
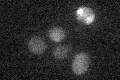

View description
Nuclear transcription factor with two Cys2-His2 zinc fingers; involved in repression of a subset of hypoxic genes by Rox1p, repression of several DAN/TIR genes during aerobic growth, and repression of ergosterol biosynthetic genes
Localization:
Intensity:
Fold change:
Significance:
-
C’ GFP library in SD
below threshold16.25 -
N' NOP1pr-GFP in SD
nucleus34.7454 -
N' TEF2pr-mCherry in SD

nucleus8.91856 -
N' NATIVEpr-GFP in SD

nucleus35.9903 -
N' TEF2pr-VC and Cyto-VN in SD
nucleus31.5144 -
C’ GFP library in SD+DTT
cytosol15.520.95No -
C’ GFP library in SD+H2O2

cytosol16.581.02No -
C’ GFP library in Starvation Media
cytosol14.670.9No -
C’ GFP library on the background of Pup2-DaMP

below threshold -
C’ GFP library on the background of CCT mutant

below threshold16.23240.998661No
